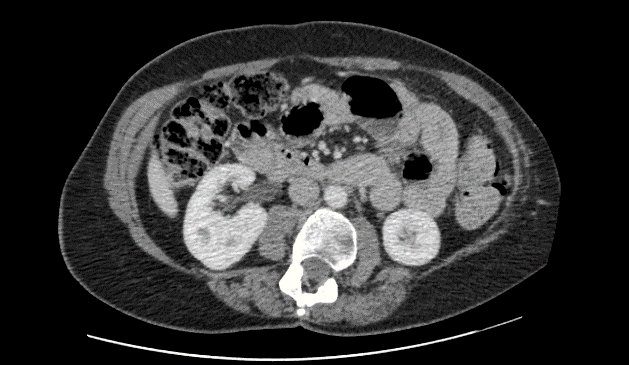
Science Repository

Laparoscopic Intraperitoneal Onlay Mesh (IPOM) Repair with Biological Mesh for Secondary Lumbar Hernia
A B S T R A C T
This manuscript presents the first case of lumbar hernia repair using a biological mesh. The patient presented with secondary lumbar hernia after surgery for scoliosis. A laparoscopic approach was performed with bovine dermal collagen matrix mesh fixed with cyanoacrylate glue. The patient was followed up to 34 months post-surgery with no evidence of recurrence.
Keywords
Lumbar hernia, biological mesh, laparoscopic repair
Introduction
Lumbar hernias arise from defects in the abdominal wall in the lumbar region. These can be categorised by anatomical location or aetiology. Anatomical location is categorised by herniation through the superior lumbar triangle (Grynfeltt-Lesshaft hernia) or the inferior lumbar triangle (Petit hernia). Aetiology can be categorised into congenital or acquired and acquired lumbar hernias can be further subdivided into primary or secondary. Primary acquired lumbar hernias are very rare, with only around 300 cases recorded since records began [1]. Secondary acquired lumbar hernias are relatively more common, and are associated with iatrogenic surgical incision, liver abscesses, infected retroperitoneal haematomas, and trauma. Rates of 3-10% have been reported with surgical flank approaches, such as for abdominal aortic aneurysm surgery, scoliosis surgery, and open nephrectomy [2, 3]. This may be a combination of the incision itself and the dissection of the subcostal nerve during surgery, leading to muscle atrophy. These patients usually present with symptoms such as backache, pain, and swelling over the hernia site, and depending on hernia contents, can lead to complications such as urinary obstruction, bowel obstruction, incarceration, and strangulation [4].
The diagnosis pathway for a lumbar hernia is first through analysis of the patient’s history, careful physical examination, followed by confirmation through a CT scan [4]. Once diagnosed, lumbar hernias can be managed either conservatively or surgically, but definitive management requires surgical repair. Indications for surgical repair include consideration of the severity of symptoms and their effects on the patient. As these hernias normally grow in size over time, leading to more severe symptoms and increasing difficulty of repair, many surgeons advocate early repair providing low surgical risk [5]. Classically, the open approach has been used for lumbar hernia repair, by closing the hernia directly or through the use of a prosthetic mesh. Recently, laparoscopic repair involving either the intra-abdominal or extraperitoneal approach has emerged as another option [6]. There is no definitive consensus as to the optimal surgical approach, possibly due to the limited number of cases of lumbar hernia repair in the scientific literature. Currently, laparoscopic repair with mesh appears to be the most favoured approach [7, 8]. One prospective study comparing open with laparoscopic repair showed that laparoscopic surgery was associated with significantly reduced morbidity and shorter length of hospital stay [9].
In the laparoscopic approach, the patient is placed in the lateral decubitus position with the table flexed. The abdominal cavity is accessed through three port sites, one in the umbilicus and two in the upper and lower abdomen. The hernia is then reduced depending on its contents: for the colon, the peritoneal reflection is opened, leading to reduction with gravity [10]. A prosthetic mesh is measured according to the size of the defect, aiming for a 3-5cm overlap with the abdominal wall [9]. The mesh is then secured with sutures or spiral tacks, followed by replacement of preperitoneal fat, and closure of the peritoneum [10-13]. All case studies involving lumbar hernia repair with a mesh have used a synthetic mesh, often ePTFE or polypropylene. Biological mesh consists of decellularised human, bovine or porcine tissue which forms a collagen matrix. This is designed to incorporate into existing tissue over time and has less risk of erosion into adjacent structures compared to polypropylene mesh [14]. There has been no record of a biological mesh used in lumbar hernia repair in the literature.
Case Report
A 60-year-old female was assessed in pre op clinic for management of her symptomatic left lumbar incisional hernia. She presented with a lumbar bulge after surgery for scoliosis aged 17. The lumbar bulge could be reduced manually. Abdominal CT confirmed a left lumbar incisional hernia containing ascending colon, but no signs of obstruction or strangulation (Figure 1). During the consultation, a decision was made for an elective lumbar hernia repair. The patient provided consent for the anonymous publication of this case and accompanying images.
Figure 1: CT scan performed pre-operation (August 2016) showing left lumbar hernia.
4 months later, laparoscopic left lumbar incisional hernia repair with biological mesh was carried out under general anaesthesia. A left lumbar defect which measured 18cm x 6cm was identified. The defect was closed with ten Ethibond® No 5 (Ethicon) interrupted trans fascial sutures. A laparoscopic IPOM repair was carried out using a 1.0mm thickness, 20cm x 16cm mesh formed from bovine dermal collagen matrix (Surgimend® [Integra]) which was fixed with Prolene® (Ethicon) 2/0 stays medially, laterally, and centrally. Cyanoacrylate glue (Liquiband Fix8® [Advanced Medical Solutions plc]) was used for mesh fixation to over the iliac crest, costal margin, centrally (to obliterate the dead space between mesh and peritoneum) and all other edges (Figures 2-4). There were no complications intra-operatively. Post-operatively, the patient was settled on the ward with thoracic epidural analgesia for 4 days and was discharged home 5 days after the operation.
Figure 2: Laparoscopic IPOM repair – the biologic mesh is fixed to the costal margin using cyanoacrylate glue.
Figure 3: Laparoscopic IPOM repair – the biologic mesh is fixed centrally using cyanoacrylate glue to obliterate the dead space between mesh and peritoneum.
Figure 4: Laparoscopic IPOM repair – the biologic mesh is fixed to the iliac crest using cyanoacrylate glue.
At 15 months post-op examination of the repair site and CT of the abdomen revealed no evidence of seroma or recurrent hernia (Figure 5). The patient was reporting a degree of pain at the repair site. At 18 months post-operation, eight Ethibond® (Ethicon) transfascial sutures were removed under general anaesthetic as a day case, which relieved the majority of her symptoms. Further follow up of the patient (to 34 months post-op) has shown no clinical or radiological hernia recurrence (Figure 6).
Figure 5: CT scan transverse image performed 15 months post-operation.
Conclusion
This novel technique of laparoscopic IPOM repair using biologic mesh for repair of a secondary lumbar hernia appears to be safe and effective with low risk of post-op complications.
Article Info
Article Type
Case ReportPublication history
Received: Mon 16, Dec 2019Accepted: Wed 26, Feb 2020
Published: Sat 29, Feb 2020
Copyright
© 2023 Han J. This is an open-access article distributed under the terms of the Creative Commons Attribution License, which permits unrestricted use, distribution, and reproduction in any medium, provided the original author and source are credited. Hosting by Science Repository.DOI: 10.31487/j.SCR.2020.02.11
Author Info
Corresponding Author
Han JDepartment of General Surgery, Royal Lancaster Infirmary, Lancaster LA1 4RP, UK
Figures & Tables

References
- Ploneda Valencia CF, Cordero Estrada E, Castañeda González LG, Sainz Escarrega VH, VarelaMuñoz O et al. (2016) Grynfelt-Lesshaft hernia a case report and review of the literature. Ann Med Surg (Lond) 7: 104-106. [Crossref]
- Inkiläinen A, Styrke J, Ljungberg B, Strigård K (2018) Occurrence of abdominal bulging and hernia after open partial nephrectomy: a retrospective cohort study. Scand J Urol 52: 54-58. [Crossref]
- Osman T, Emam A, Farouk A, ElSaeed K, Tawfeek AM et al. (2018) Risk factors for the development of flank hernias and bulges following surgical flank approaches to the kidney in adults. Arab J Urol 16: 453-459. [Crossref]
- Moreno Egea A, Baena EG, Calle MC, Martínez JA, Albasini JL (2007) Controversies in the current management of lumbar hernias. Arch Surg 142: 82-88. [Crossref]
- Orcutt TW (1971) Hernia of the superior lumbar triangle. Ann Surg 173: 294-297. [Crossref]
- Stamatiou D, Skandalakis JE, Skandalakis LJ, Mirilas P (2009) Lumbar hernia: surgical anatomy, embryology, and technique of repair. Am Surg 75: 202-207. [Crossref]
- Krivan S, Rashid F (2019) Laparoscopic Repair of Lumbar Hernia: A Case Report and Mini Review. Hellen J Surg 91: 105-109.
- Suarez S, Hernandez JD (2013) Laparoscopic repair of a lumbar hernia: report of a case and extensive review of the literature. Surg Endosc 27: 3421-3429. [Crossref]
- Moreno Egea A, Torralba Martinez JA, Morales G, Fernández T, Girela E et al. (2005) Open vs laparoscopic repair of secondary lumbar hernias: a prospective nonrandomized study. Surg Endosc 19: 184-187. [Crossref]
- Salameh JR, Salloum EJ (2004) Lumbar incisional hernias: diagnostic and management dilemma. JSLS 8: 391-394. [Crossref]
- Postema PP, Bonjer HJ (2002) Endoscopic extraperitoneal repair of a Grynfeltt hernia. Surg Endosc 16: 716. [Crossref]
- Claus CMP, Nassif LT, Aguilera YS, Ramos EB, Coelho JCU (2017) LAPAROSCOPIC REPAIR OF LUMBAR HERNIA (GRYNFELT): TECHNICAL DESCRIPTION. Arq Bras Cir Dig 30: 56-59. [Crossref]
- Tobias Machado M, Rincon FJ, Lasmar MT, Zambon JP, Juliano RV et al. (2005) Laparoscopic surgery for treatment of incisional lumbar hernia. Int Braz J Urol 31: 309-314. [Crossref]
- FitzGerald JF, Kumar AS (2014) Biologic versus Synthetic Mesh Reinforcement: What are the Pros and Cons? Clin Colon Rectal Surg 27: 140-148. [Crossref]
